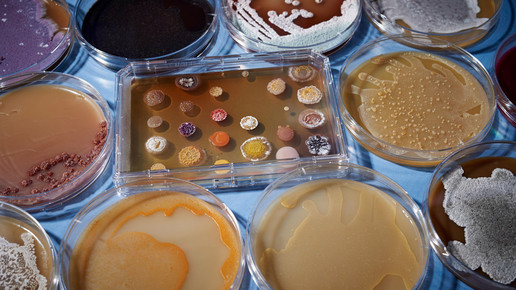
sanofi antibiotika 02 sanofi

Fluorchinolone: EMA plant öffentliche Anhörung
Chinolone und Fluorchinolone in Diskussion: Im Sommer soll im Rahmen der Neubewertung eine öffentliche Anhörung zu den risikobehafteten Antibiotika stattfinden. Organisiert wird das von der Europäischen Arzneimittelagentur (EMA).
Das Bundesinstitut für Arzneimittel und Medizinprodukte (BfArM) hatte kürzlich ein europäisches Risikobewertungsverfahren für Antibiotika aus der Gruppe der Fluorchinolone und Chinolone angestoßen. Ziel ist eine umfassende Bewertung von schwerwiegenden Nebenwirkungen, die zu starken Einschränkungen und unter Umständen zu irreversiblen Schäden führen können. Dazu soll die aktuelle wissenschaftliche Literatur analysiert werden. So wollen die Experten feststellen, welche Effekte diese unerwünschten Arzneimittelwirkungen für Nutzen-Risiko-Verhältnis haben. Auch wird überprüft, ob weitere Maßnahmen zur Risikominimierung erforderlich sind.
Der Ausschuss für Risikobewertung im Bereich der Pharmakovigilanz (PRAC) der Europäischen Arzneimittelagentur (EMA) hat nun entschieden, im Rahmen des Bewertungsverfahrens der genannten Antibiotika eine öffentliche Anhörung zu organisieren, die für die Zeit während der Tagung des Ausschusses im Juni 2018 geplant ist. Dadurch sollen die Erfahrungen der interessierten Parteien in die Empfehlung des Ausschusses mit einbezogen werden.
Hintergrund für diese Entscheidung sei das wachsende öffentliche Interesse an der Sicherheit dieser Arzneimittel. Mit der Anhörung soll ein besseres Verständnis für die Ansichten der Öffentlichkeit zu den Risiken, die mit dem Gebrauch dieser Antibiotika einhergehen und der Durchführbarkeit bestimmter Maßnahmen zur Optimierung des sicheren Gebrauchs erhalten werden. Chinolone sind in Deutschland zwar nicht mehr zugelassen, jedoch in anderen europäischen Ländern verfügbar.

APOTHEKE ADHOC Debatte